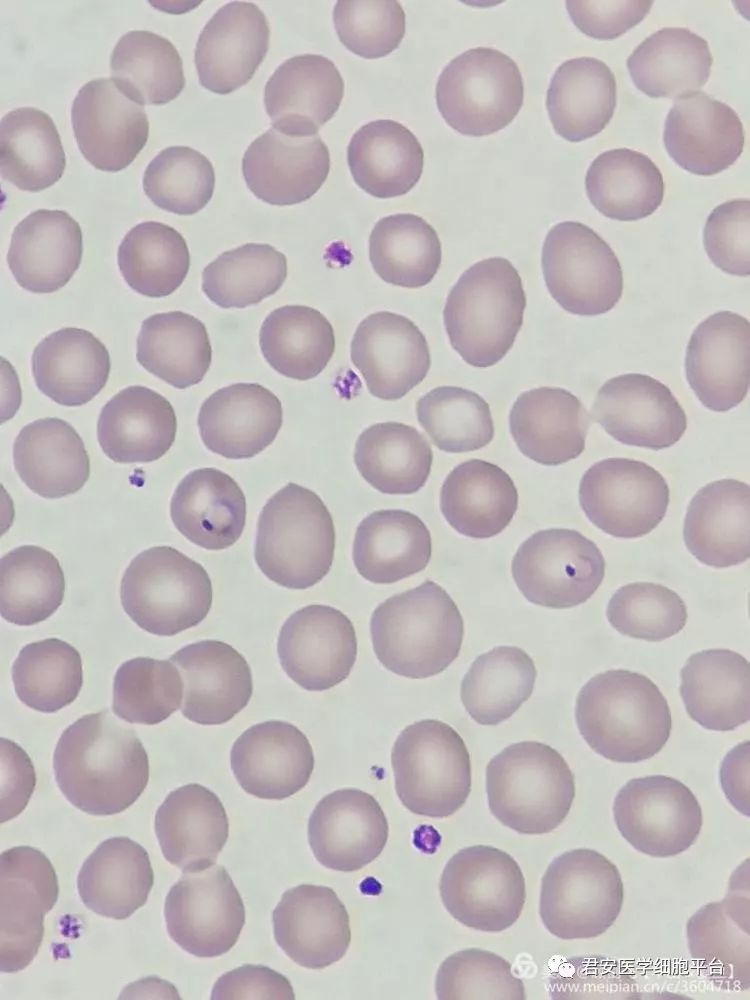
发热待查的喀麦隆归者_疟原虫

恶性疟原虫雌雄配子体(2)
2022-03-02 来源:动态图库网

间日疟原虫配子体(雌)
间日疟原虫雄配子体 恶性疟原虫环状体 恶性疟原虫雌配子体 恶性
所有的疟原虫都发源于非洲,为何间日疟却被赶出了老家?
绝对干货分享—《疟原虫检测技术》
薄血膜间日疟原虫和恶性疟原虫基本结构和形态鉴别挂图
人红细胞中的恶性疟原虫配子体,图片来自eva hitz/swiss tph.
疟原虫形态图谱.doc
恶性疟原虫环状体
恶性疟原虫配子体(雄)
恶性疟原虫配子体,弓形虫滋养体,杜氏利什曼原虫,荚膜
发热待查的喀麦隆归者_疟原虫
08 ▼ 「间日疟原虫雌配子体」 形态特征:感染虫体的红细胞胀大,外形
恶性疟原虫 plasmodium falciparum. 图片来自网络.
恶性疟原虫雄配子子体手绘图